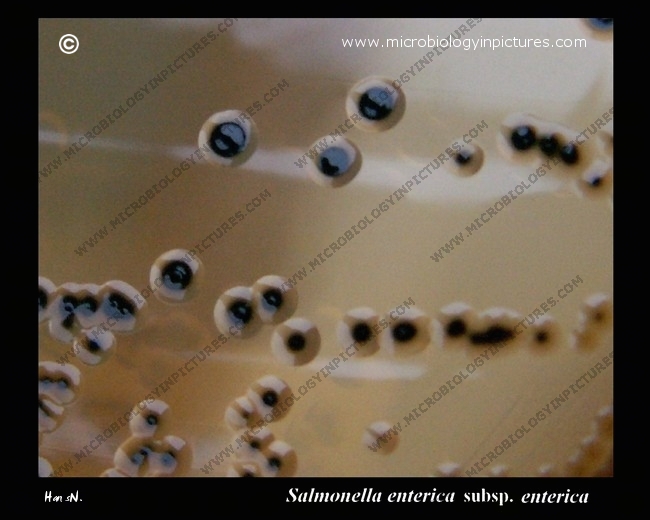
salmonella colonies on salmonella-shigella agar, close-up

Salmonella enterica on salmonella-shigella agar. H2S-positive, lactose-negative colonies. Cultivation 24 hours, 37°C.
Salmonella-shigella agar is a differentially selective medium for the isolation of pathogenic enteric bacteria, especially those belonging to the genus Salmonella (SS agar is not recommended for the primary isolation of Shigella spp.; some strains may not grow due to the relatively high level of selectivity).
